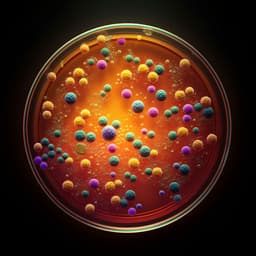

Social Work
Navigating the terrain of caregiving of children with intellectual and developmental disabilities: importance of benefit finding and optimism
P. S. J. Singh, A. Azman, et al.
This captivating qualitative study investigates how benefit finding and optimism empower caregivers of children with intellectual and developmental disabilities in Malaysia. Through interviews with twenty caregivers, the research sheds light on how these strategies foster personal growth, enhance relationships, and illuminate spirituality. The authors recommend focused interventions to bolster these vital coping mechanisms, led by Paramjit Singh Jamir Singh, Azlinda Azman, Syazwani Drani, Mohd Iqbal Haqim Mohd Nor, and Aznan Che Ahmad.
~3 min • Beginner • English
Related Publications
Explore these studies to deepen your understanding of the subject.